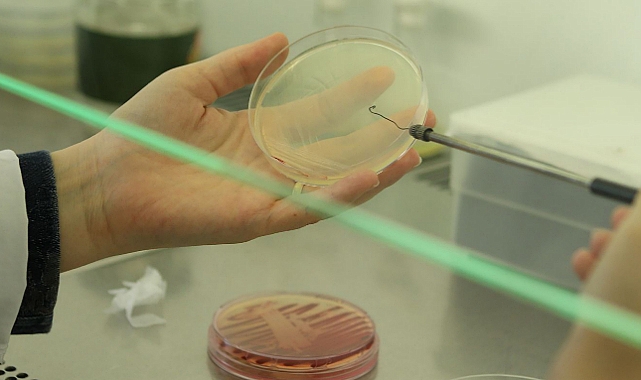

TÜBİTAK KMÜ’NÜN 16 PROJESİNE DESTEK VERECEK
KMÜ ÖĞRENCİLERİ TÜBİTAK 2209-A PROGRAMI KAPSAMINDA DESTEK ALMAYA HAK KAZANDI
TÜBİTAK Bilim İnsanı Destek Programları Başkanlığı (BİDEB) tarafından yürütülen “2209-A Üniversite Öğrencileri Araştırma Projeleri Destekleme Programı” 2023 Yılı 2. Dönem çağrısı destek sonuçlarını açıklandı.
2209-A Programı 2023/2. dönem çağrı sonuçlarına göre Karamanoğlu Mehmetbey Üniversitesi’nin (KMÜ) 16 projesi destek almaya hak kazandı.
'2209-A Üniversite Öğrencileri Araştırma Projeleri Destekleme Programı' kapsamında yapılan başvurular sonucunda Edebiyat Fakültesi Öğretim Üyesi Doç. Dr. Mehmet Çakır, Mühendislik Fakültesi Dr. Ögr. Üyesi Güliz Toz ve Dr. Ögr. Üyesi Cemaleddin Şimşek, Sağlık Bilimleri Fakültesi Dr. Ögr. Üyesi Orkun Erkayıran, Dr. Ögr. Üyesi Demet Çelik, Dr. Ögr. Üyesi Özlem Yılmaz Demirel ve Dr. Ögr. Üyesi Şemsi Gül Yılmaz, Sağlık Hizmetleri Meslek Yüksekokulu Öğr. Gör. Hatice Çağla Özdamar, Spor Bilimleri Fakültesi Öğretim Üyeleri Prof. Dr. Murat Tekin, Prof. Dr. Mehmet Dalkılıç, Doç. Dr. Veysel Temel ve Doç. Dr. Erhan Devrilmez, Teknik Bilimler Meslek Yüksekokulu Öğr. Gör. Kutlu Çevik ile Tıp Fakültesi Öğretim Üyesi Doç. Dr. Abdülhadi Cihangir Uğuz’un danışmanlığını yaptığı 16 öğrenci projesi TÜBİTAK tarafından desteklenmeye layık görüldü.
“Kıymetli akademisyenlerimizi ve öğrencilerimizi tebrik ediyorum”
2209-A Üniversite Öğrencileri Araştırma Projeleri Destekleme Programı sonuçlarının açıklanmasının ardından değerlendirmelerde bulunan KMÜ Rektörü Prof. Dr. Mehmet Gavgalı, “İnovasyonun her geçen gün daha da önem kazandığı bir dönemde yaratıcı fikirleri ve çözüm önerileri ile yazdıkları projeleri ile TÜBİTAK’tan destek almaya hak kazanan değerli öğrencilerimizi gönülden tebrik ediyorum. Öğrencilerimizi bu dönemde yalnız bırakmayan ve danışmalığı yapan kıymetli hocalarımıza da ayrıca teşekkür ediyor, başarılarının devamını diliyorum.” dedi.